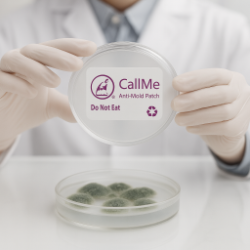

為什麼防霉產品必須讓使用者知道它是否在作用?
克美防霉片
氣體殺菌,全面守護每一件商品
克美防霉片採用先進氣體殺菌技術,所釋放的防霉氣體能有效滅除空氣中的黴菌孢子,打造無菌保護空間。只要商品與防霉片同時包裝,氣體即可滲透至每個角落,形成無死角防護網,防止黴菌滋生與侵害。
更貼心的是,防霉氣體會呈現明顯作用指示,使用者可以直觀感受防霉片正在運作,方便判別產品是否受到有效保護。這種非接觸式防霉方式不僅安全環保,還能確保產品在整個物流與儲存過程中保持零死角保護,給客戶帶來安心可靠的使用體驗。

信任與安心感
使用者能清楚知道產品正在發揮防霉作用,才會真正放心。 品牌端與客戶也能因可視化的效果而增加信任。
即時判斷與風險控制
如果防霉產品已經失效或超過有效期,但使用者不知情,可能導致貨物在出貨或運輸途中發霉。 能判斷作用狀態的產品,可以幫助工廠及時更換,避免風險擴大。
提升品質管理
防霉管理不只是「放一片產品」而已,而是需要科學化與數據化。 當使用者能確認防霉產品的作用狀態,就能更好地追蹤、記錄,提升整體品控流程。
符合品牌與國際客戶的要求
越來越多國際品牌要求供應鏈具備透明性與可追溯性。 防霉產品的作用狀態能夠被清楚展示,正是符合 合規 (Compliance) 與 永續 (Sustainability) 的重要表現。一個感受不到、無法確認的防霉產品,只能帶來「被動的僥倖」。
而一個能讓使用者清楚知道其 是否正在作用、是否仍在有效期 的防霉產品,
才是真正能為 工廠、品牌與消費者 帶來 可控、可靠、可追溯 的安心保障。
透明化 = 信任 + 品質 + 永續。
產品規格
| 品名 | 尺寸 |
|---|---|
| CALL ME PAPER / SUPER CLEAN | 房型5*3cm |
| CALL ME PE | 房型5*4cm |
| CLEAN MOLD | 房型5*5cm |


新產品
可持續性: 百分之百可回收
安全性:100%純天然抗黴
Call Me Paper 防霉片:
純紙張結構,無使用任何塑膠材質,滿足市場現在急需的降低塑料的需求
Call Me PE 防霉片:
純PE材質,可直接黏貼在膠袋上使用。此防霉片可與膠袋一同回收,縮短回收處理時間

可回收

可持續性

安全

簡單
適用範圍

成衣

鞋類

配件

盒裝

袋裝
使用方式
請參照克美防霉片操作說明書或洽克美諮詢

使用操作盒

撕出所需用量的防霉片

放入包裝

封入外箱
測試報告

第三方實驗室認證
克美防霉片通過Satra、SGS、Intertek、PFI…防霉檢測及毒物檢測。
效能檢測
經實驗證明,克美防霉片可有效抑制黴菌,通過大空間及長時間的嚴苛實驗。
毒物檢測
合乎美國及歐盟的毒物法規規範。